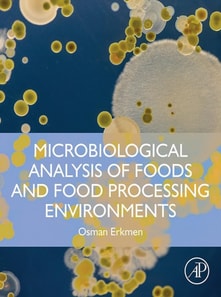
Microbiological Analysis of Foods and Food Processing Environments

Microbiological Analysis of Foods and Food Processing Environments
Available
Microbiological Analysis of Foods and Food Processing Environments is a well-rounded text that focuses on food microbiology laboratory applications. The book provides detailed steps and effective visual representations with microbial morphology that are designed to be easily understood. Sections discuss the importance of the characteristics of microorganisms in isolation and enumeration of microor...
Read more
E-book
pdf
Price
155.00 £
Microbiological Analysis of Foods and Food Processing Environments is a well-rounded text that focuses on food microbiology laboratory applications. The book provides detailed steps and effective visual representations with microbial morphology that are designed to be easily understood. Sections discuss the importance of the characteristics of microorganisms in isolation and enumeration of microor...
Read more
Follow the Author
